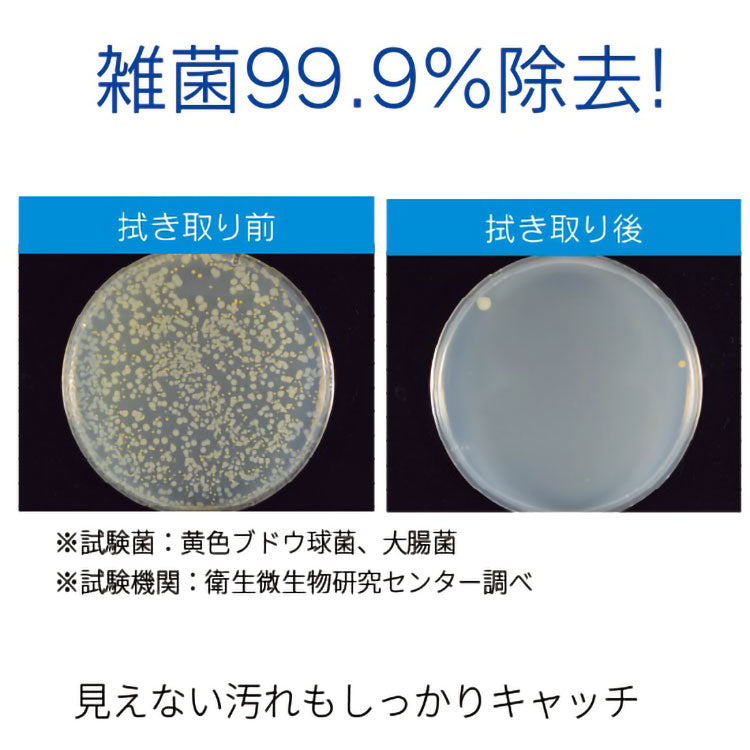

1
/
の
15
SKU:dd-4906064275803
CCP コードレス回転モップクリーナー Neo+ Brisa 電動 防水仕様 拭き掃除 水拭き モップ掃除 繰り返し 長さ調節 自立式 軽量 フローリング 屋内 屋外 お風呂 窓 網戸 玄関 壁 庭 充電式 ZJ-MA42-WH
CCP コードレス回転モップクリーナー Neo+ Brisa 電動 防水仕様 拭き掃除 水拭き モップ掃除 繰り返し 長さ調節 自立式 軽量 フローリング 屋内 屋外 お風呂 窓 網戸 玄関 壁 庭 充電式 ZJ-MA42-WH
No reviews
通常価格
¥11,000
通常価格
セール価格
¥11,000
税込。
配送料はチェックアウト時に計算されます。
数量
受取状況を読み込めませんでした
●極細繊維とコシのある繊維の2重繊維構造で、水だけで汚れを取りきります。
●1分あたりの回転数は2段階で調節可能(強モード:200回転/標準モード:100回転)
●防水仕様のため、水をかけながら掃除が可能。お風呂の床面やお庭などお掃除の幅が広がります。
●汚れを見やすくするためにモップパッドはホワイトへ変更しました。
●モップはマジックテープ式で簡単取り外し。洗って乾かせば何度でも使えます。
●壁際までモップが届いて上手にお掃除が可能。ハンディにもなる長さ2段階。
●自立式
【仕様】
電源:リチウムイオンバッテリー
充電器:入力…AC100V 50/60Hz・出力…DC9V/500mA
使用電池:充電式リチウムイオンバッテリー7.4V
充電時間:約4.5時間
連続運転時間:モップパッドドライ時…強モード 約60分/標準モード 約90分・モップパッドウェット時…強モード 約45分/標準モード 約65分
モップパッド直径:約16cm
ACアダプターコード長さ:約1.5m
付属品:ACアダプタ, モップ
商品の重量:約1.1kg
【商品変更日】
2024年11月20日
【変更箇所】
型番:ZJ-MA21-WH→TZJ-MA951-WH
JANコード:4906064273946→4906064273182
追加機能:LEDライト搭載
1分間あたりのモップ回転率:150回→130回
【商品変更日】
2026年1月23日
【変更箇所】
型番:TZJ-MA951-WH→ZJ-MA42-WH
JANコード:4906064273182→4906064275803
削除機能:LEDライト
追加機能:防水対応
1分間あたりのモップ回転率:130回→100/200回の2段階
本体重量:約1.0kg→約1.1kg
充電時間:約3.5時間→約4.5時間
【送料について】
北海道、沖縄、離島は送料を頂きます。














●1分あたりの回転数は2段階で調節可能(強モード:200回転/標準モード:100回転)
●防水仕様のため、水をかけながら掃除が可能。お風呂の床面やお庭などお掃除の幅が広がります。
●汚れを見やすくするためにモップパッドはホワイトへ変更しました。
●モップはマジックテープ式で簡単取り外し。洗って乾かせば何度でも使えます。
●壁際までモップが届いて上手にお掃除が可能。ハンディにもなる長さ2段階。
●自立式
【仕様】
電源:リチウムイオンバッテリー
充電器:入力…AC100V 50/60Hz・出力…DC9V/500mA
使用電池:充電式リチウムイオンバッテリー7.4V
充電時間:約4.5時間
連続運転時間:モップパッドドライ時…強モード 約60分/標準モード 約90分・モップパッドウェット時…強モード 約45分/標準モード 約65分
モップパッド直径:約16cm
ACアダプターコード長さ:約1.5m
付属品:ACアダプタ, モップ
商品の重量:約1.1kg
【商品変更日】
2024年11月20日
【変更箇所】
型番:ZJ-MA21-WH→TZJ-MA951-WH
JANコード:4906064273946→4906064273182
追加機能:LEDライト搭載
1分間あたりのモップ回転率:150回→130回
【商品変更日】
2026年1月23日
【変更箇所】
型番:TZJ-MA951-WH→ZJ-MA42-WH
JANコード:4906064273182→4906064275803
削除機能:LEDライト
追加機能:防水対応
1分間あたりのモップ回転率:130回→100/200回の2段階
本体重量:約1.0kg→約1.1kg
充電時間:約3.5時間→約4.5時間
【送料について】
北海道、沖縄、離島は送料を頂きます。














Share















あなたにオススメの商品
-
-
【5%OFF】トイレットペーパーホルダー おしゃれ スタイリッシュ 落下防止 トイレットペーパー置き 壁掛け ヴィンテージ 収納付き 棚付き 天然木 アイアン
通常価格 ¥6,631通常価格¥6,980セール価格 ¥6,631セール -
【5%OFF】トイレットペーパーホルダー ダブルタイプ 2連 天板 オールスチール スチール 耐荷重5kg 棚付き 飾り棚 おしゃれ モダン トイレ 収納 賃貸 トイレ収納 トイレ用品
通常価格 ¥1,899通常価格¥1,999セール価格 ¥1,899セール -